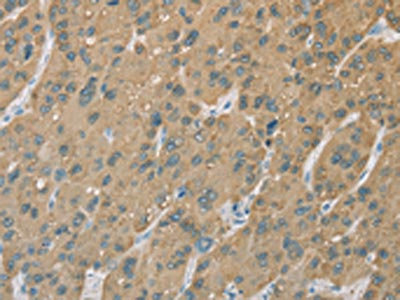

CYP2C9 Antibody
-
中文名稱:CYP2C9兔多克隆抗體
-
貨號:CSB-PA106326
-
規(guī)格:¥1100
-
圖片:
-
The image on the left is immunohistochemistry of paraffin-embedded Human liver cancer tissue using CSB-PA106326(CYP2C9 Antibody) at dilution 1/50, on the right is treated with fusion protein. (Original magnification: ×200)
-
The image on the left is immunohistochemistry of paraffin-embedded Human gastric cancer tissue using CSB-PA106326(CYP2C9 Antibody) at dilution 1/50, on the right is treated with fusion protein. (Original magnification: ×200)
-
-
其他:
產(chǎn)品詳情
-
Uniprot No.:
-
基因名:CYP2C9
-
別名:(R)-limonene 6-monooxygenase antibody; (S)-limonene 6-monooxygenase antibody; (S)-limonene 7-monooxygenase antibody; CP2C9_HUMAN antibody; CPC9 antibody; CYP2C antibody; CYP2C10 antibody; CYP2C9 antibody; CYPIIC9 antibody; cytochrome P-450 S-mephenytoin 4-hydroxylase antibody; Cytochrome P-450MP antibody; Cytochrome P450 2C9 antibody; Cytochrome P450 MP-4 antibody; Cytochrome P450 MP-8 antibody; Cytochrome P450 PB-1 antibody; Cytochrome P450; family 2; subfamily C; polypeptide 9 antibody; Cytochrome p4502C9 antibody; flavoprotein-linked monooxygenase antibody; MGC149605 antibody; MGC88320 antibody; microsomal monooxygenase antibody; OTTHUMP00000020135 antibody; P450 MP antibody; P450 PB 1 antibody; P450 PB1 antibody; P450IIC9 antibody; P450MP antibody; S mephenytoin 4 hydroxylase antibody; S-mephenytoin 4-hydroxylase antibody; xenobiotic monooxygenase antibody
-
宿主:Rabbit
-
反應(yīng)種屬:Human
-
免疫原:Fusion protein of Human CYP2C9
-
免疫原種屬:Homo sapiens (Human)
-
標(biāo)記方式:Non-conjugated
-
抗體亞型:IgG
-
純化方式:Antigen affinity purification
-
濃度:It differs from different batches. Please contact us to confirm it.
-
保存緩沖液:-20°C, pH7.4 PBS, 0.05% NaN3, 40% Glycerol
-
產(chǎn)品提供形式:Liquid
-
應(yīng)用范圍:ELISA,IHC
-
推薦稀釋比:
Application Recommended Dilution ELISA 1:2000-1:5000 IHC 1:50-1:200 -
Protocols:
-
儲存條件:Upon receipt, store at -20°C or -80°C. Avoid repeated freeze.
-
貨期:Basically, we can dispatch the products out in 1-3 working days after receiving your orders. Delivery time maybe differs from different purchasing way or location, please kindly consult your local distributors for specific delivery time.
-
用途:For Research Use Only. Not for use in diagnostic or therapeutic procedures.
相關(guān)產(chǎn)品
靶點(diǎn)詳情
-
功能:A cytochrome P450 monooxygenase involved in the metabolism of various endogenous substrates, including fatty acids and steroids. Mechanistically, uses molecular oxygen inserting one oxygen atom into a substrate, and reducing the second into a water molecule, with two electrons provided by NADPH via cytochrome P450 reductase (NADPH--hemoprotein reductase). Catalyzes the epoxidation of double bonds of polyunsaturated fatty acids (PUFA). Catalyzes the hydroxylation of carbon-hydrogen bonds. Metabolizes cholesterol toward 25-hydroxycholesterol, a physiological regulator of cellular cholesterol homeostasis. Exhibits low catalytic activity for the formation of catechol estrogens from 17beta-estradiol (E2) and estrone (E1), namely 2-hydroxy E1 and E2. Catalyzes bisallylic hydroxylation and hydroxylation with double-bond migration of polyunsaturated fatty acids (PUFA). Also metabolizes plant monoterpenes such as limonene. Oxygenates (R)- and (S)-limonene to produce carveol and perillyl alcohol. Contributes to the wide pharmacokinetics variability of the metabolism of drugs such as S-warfarin, diclofenac, phenytoin, tolbutamide and losartan.
-
基因功能參考文獻(xiàn):
- Molecular dynamics simulations performed for the active species of the enzyme (heme in the Compound I state), in the apo or substrate-bound state, and binding energy analyses gave insights into altered protein structure and dynamics involved in the defective drug metabolism of human allelic variant CYP2C9*30 (A477T). PMID: 29746595
- Lower expression of CYP2C9 was associated with better overall survival and disease-free survival in Hepatocellular carcinoma tumor samples. PMID: 29974848
- A significant association between CYP2C9*3 and phenytoin-induced Stevens-Johnson syndrome was identified, especially in a Thai population (Meta-Analysis) PMID: 29274302
- In this study, we showed that patients with VKORC1-1639GA and CYP2C9*1/*1 alleles have lower sensitivity for warfarin than those with VKORC1-1639AA and CYP2C9*1/*1 alleles. PMID: 29781049
- Enzyme phenotyping with correlation analysis confirmed the predominant role of CYP2C9 in the biotransformation of siponimod and demonstrated the functional consequence of CYP2C9 genetic polymorphisms and fluconazole on siponimod metabolism. PMID: 29273968
- Comparisons of pharmacokinetics of 25 substrates CYP2C9, CYP2C19, or CYP2D6 in healthy Chinese and European subjects (classified with same enzyme activity) suggest that, for most substrates, limited interethnic pharmacokinetic differences exist (according to the databases used in this study). (CYP2C19 = cytochrome P450 family 2 subfamily C member 19; CYP2D6 = cytochrome P450 family 2 subfamily D member 6) PMID: 29181698
- genetic association studies in population in Scotland: data suggest, in type 2 diabetes treated with sulfonylureas, 2 SNPs in CYP2C9 (CYP2C9*2, R144C, rs1799853; CYP2C9*3, I359L, rs1057910) are associated with drug-induced hypoglycemia; an SNP in POR (POR*28, A503V, rs1057868) is associated with better response to sulfonylureas. (CYP2C9 = cytochrome P450 family 2 subfamily C member 9; POR = cytochrome p450 oxidoreductase) PMID: 28656666
- The plasma S-warfarin (Cp(S)) time courses following the genotype-based dosing algorithms simulated using the PPK estimates showed African Americans with CYP2C9*1/*1 and any of the VKORC1 genotypes would have an average Cp(S) at steady state 1.5-1.8 times higher than in Asians and whites. PMID: 27503578
- The final regression models for White and Black patients (Fig. 1) included age, weight, prosthetic valves, amiodarone use, CYP2C9*3, and VKORC1 3673 G>A genotypes as covariates, whereas possession of CYP2C9*2 and simvastatin use were retained in the final model for White, but not Black patients. PMID: 28263279
- Our results further support a minor contribution of CYP2C9 genetic variability toward steady-state endoxifen concentrations. Integration of clinician and genetic variables into individualized tamoxifen dosing algorithms would marginally improve their accuracy and potentially enhance tamoxifen treatment outcomes. PMID: 28877533
- CYP2C9 genetic variation was associated with long-term overall mortality and non-major bleeding in elderly patients treated with vitamin K antagonists. PMID: 28834238
- Until the age of 19, weight has a far greater effect on Vitamin K antagonist dosing variation than VKORC1 and CYP2C9 polymorphisms. During the age of 20-40years, VKORC1 and CYP2C9 polymorphisms play a significant role. PMID: 28284562
- CYP2C9*3 did show significant effect on warfarin dose requirement PMID: 27313202
- Two SNPs in CYP2C9, rs2153628 and rs1799853 are associated with response to indomethacin for the treatment patent ductus arteriosus. PMID: 28609430
- the carriership of individual C and T alleles in the case of CYP2C9*2 gene, as well as A and C for CYP2C9*3 is not a predictor of antiretroviral drug-induced liver injury. PMID: 29787666
- Genetic polymorphisms in CYP2C9 cause significant interindividual variability in the metabolism of its substrates. This study estimated the coefficient of variation (CV) for the intrinsic hepatic clearance of tolbutamide by CYP2C9 for each CYP2C9 genotype using previously reported area under the blood concentration curve (AUC) and oral clearance (CLoral) values in a Monte Carlo simulation with a dispersion model. PMID: 28435143
- These results suggest that genetic polymorphisms of CYP2C9 enzymes result in the production of varying levels of biologically active JWH-018 metabolites in some individuals, offering a mechanistic explanation for the diverse clinical toxicity often observed following JWH-018 abuse. PMID: 29522717
- Studied the association of CYP2C9*2 (430C/T), *3 (1075A/C) and VKORC1 (-1639G/A) polymorphisms on warfarin dose requirements in patients post cardiac valve surgery. Found age and presence of CYP2C9 *2 allele significantly affect the daily dosage of warfarin during initiation of warfarin therapy after cardiac valve replacement surgery. PMID: 29182754
- CYP2C9 mutations had a significant impact on 2-propyl-4-pentenoic acid concentration PMID: 28315807
- Angiotensin II receptor blockers exhibit different degrees of inhibition of the metabolism of arachidonic acid by recombinant CYP2C9, CYP2J2 and liver microsomes. PMID: 28374982
- analysis of VKORC1 AA-CYP2C9*1*1 genotypes reveals dosing algorithms for vitamin K antagonists PMID: 28063245
- To investigate whether the CYP2C9*2 and *3 variants modify benzodiazepine-related fall risk. CYP2C9*2 and *3 allele variants modify benzodiazepine-related fall risk. Those using benzodiazepines and having reduced CYP2C9 enzyme activity based on their genotype are at increased fall risk. PMID: 27889507
- In an Indian population of children with epilepsy on phenytoin monotherapy, CYP2C9*1, *2 & *3 allelic frequencies were 85.4, 4.5 and 10.1 % respectively. CYP2C9*3 allelic group showed significantly higher serum phenytoin levels compared to the wild variants. PMID: 27179628
- The genotype distributions of the CYP2C9*3, CYP2D6*10, and CYP3A5*3 genetic polymorphisms were associated with the warfarin maintenance dose. PMID: 28872889
- CYP2C9*2 and CYP2C9*3 genetic polymorphisms are associated with reduced S-warfarin oral clearance in healthy subjects PMID: 27878474
- Case Report: time course of CYP2C9 deinduction appeared to be delayed compared to CYP3A after discontinuation of rifampicin therapy. PMID: 28157069
- Data suggest that SNPs in CYP2C9 (*3, I359L; *30, A477T) that reduce catalytic activity of CYP2C9 also alter interaction with antihypertensive drug losartan; I359L substitution located far from active site remarkably alters residue side chains near active site and access channel, whereas the T477 substitution illustrates hydrogen-bonding interaction with reoriented side chain of Q214. PMID: 28972767
- SNP rs4918758 of CYP2C9 showed a suggestive association with decreased risk of coronary heart disease. PMID: 28687336
- CYP2C9*31075AC genotype with combined alcohol and nevirapine usage indicated a risk for development of antiretroviral-associated hepatotoxicity PMID: 28370504
- CYP2C9 polymorphisms showed no effect on PC doses. Similar findings were observed in the initiation phase of PC therapy. High complications rates under PC therapy were observed particularly at the beginning. PMID: 26984978
- Genetic variants of CYP2C9/VKORC1 and age are significant determinants of the maintenance dose of warfarin in patients with atrial fibrillation/valve replacement. PMID: 27117036
- CYP2C9*3 polymorphism genotype and allele frequency were not statistically different between the case and control Ankylosing Spondylitis groups (P>0.05). the efficacy of NSAID in treatment of AS and COX-2 gene -1290A/G and -1195G/A polymorphism were associated (all P<0.05), but it is not associated with CYP2C9 *3 polymorphism (all P>0.05). PMID: 28403136
- polymorphisms c.98T>C in the UGT1A9 and c.1075A>C in the CYP2C9 genes did not affect the pharmacokinetic profile of propofol PMID: 27826892
- Possession of CYP2C9*2 and/or CYP2C9*3 allele variants is associated with lower time of international normalized ratio (INR) in the therapeutic range (TTR) values and warfarin dose variations in aortic valve replacement patients, the latter affected also by VKORC1 c.-1693G>A polymorphism PMID: 27511999
- Three SNPs (CYP2C9 *2, *3 and VKORC1 c.-1639G > A) were genotyped by electrochemical detection using a sandwich-type format that included a 3' short thiol capture probe and a 5' ferrocene-labeled signal probe. PMID: 28083852
- Two subjects with CYP2C9PM genotype both showed markedly higher AUC, prolonged half-life, and lower CL/F for celecoxib than did subjects with CYP2C9EM and IM genotypesTwo subjects with CYP2C9PM genotype both showed markedly higher AUC0-infinity, prolonged half-life, and lower CL/F for celecoxib than did subjects with CYP2C9EM and IM genotypes PMID: 27864660
- CYP2C9 IVS8-109 T carriers showed significantly higher dose-corrected phenoytoin blood concentrations and this allele was found in a higher frequency in epileptic patients with supratherapeutic phenytoin levels. PMID: 26122019
- Med25, a variable member of the Mediator complex, is a coactivator of ligand-activated ERalpha that interacts with ERalpha through its C-terminal LXXLL motif after BPA exposure, and is functionally involved in BPA-induced transcriptional regulation of CYP2C9 expression and enzyme activity. PMID: 27273787
- Our results show that anticoagulated patients have a high risk of adverse events if they are carriers of 1 or more genetic polymorphisms in the VKORC1 (rs9923231) and CYP2C9 (rs1799853 and rs1057910) genes. PMID: 28033245
- Review/Meta-analysis: CYP2C9 gene polymorphism was significantly associated with decreased warfarin maintenance dose requirements in pediatric patients. PMID: 27661060
- The intrinsic clearance (Vmax/Km) values of all variants, with the exception of CYP2C9*2, CYP2C9*11, CYP2C9*23, CYP2C9*29, CYP2C9*34, CYP2C9*38, CYP2C9*44, CYP2C9*46 and CYP2C9*48, were significantly different from CYP2C9*1. CYP2C9*27, *40, *41, *47, *49, *51, *53, *54, *56 and N418T variant exhibited markedly larger values than CYP2C9*1. PMID: 27163851
- Report roles for CYP3A4 and CYP2C9 in sequential two-step bioactivation of diclofenac to reactive p-benzoquinone imines. PMID: 27130197
- CYP2C9*2 and *3 variants were not detected and may not be the most important genetic factor for warfarin maintenance dose among Ghanaians. PMID: 27938396
- Cyp2C9 genetic polymorphisms significantly affected the plasma concentrations of zafirlukast. PMID: 27377818
- The high frequency of CYP2C9*3 and the absence of CYP2C9*2 in Jahais suggest that genetic drift may be occurring in this ethnic group. PMID: 26402341
- VKORC1-CYP2C9 interaction can affect warfarin stable dosage. PMID: 25187307
- Results show a statistically significant association between CYP2C9*3 polymorphism and phenytoin-related Stevens-Johnson syndrome. PMID: 26928377
- P450 (Cytochrome) Oxidoreductase Gene (POR) Common Variant (POR*28) Significantly Alters CYP2C9 Activity in Swedish, But Not in Korean Healthy Subjects PMID: 26669712
- VKORC1S1639 GG and the wild type CYP2C9*1*1 genotypes are associated with the high-dose requirement for warfarin therapy. PMID: 24978953
- Patients with variant CYP2C9 are at increased risk for cyclophosphamide-induced leukopenia but may have a better chance to respond to treatment. PMID: 26894931
顯示更多
收起更多
-
亞細(xì)胞定位:Endoplasmic reticulum membrane; Peripheral membrane protein. Microsome membrane; Peripheral membrane protein.
-
蛋白家族:Cytochrome P450 family
-
數(shù)據(jù)庫鏈接:
Most popular with customers
-
-
YWHAB Recombinant Monoclonal Antibody
Applications: ELISA, WB, IHC, IF, FC
Species Reactivity: Human, Mouse, Rat
-
Phospho-YAP1 (S127) Recombinant Monoclonal Antibody
Applications: ELISA, WB, IHC
Species Reactivity: Human
-
-
-
-
-